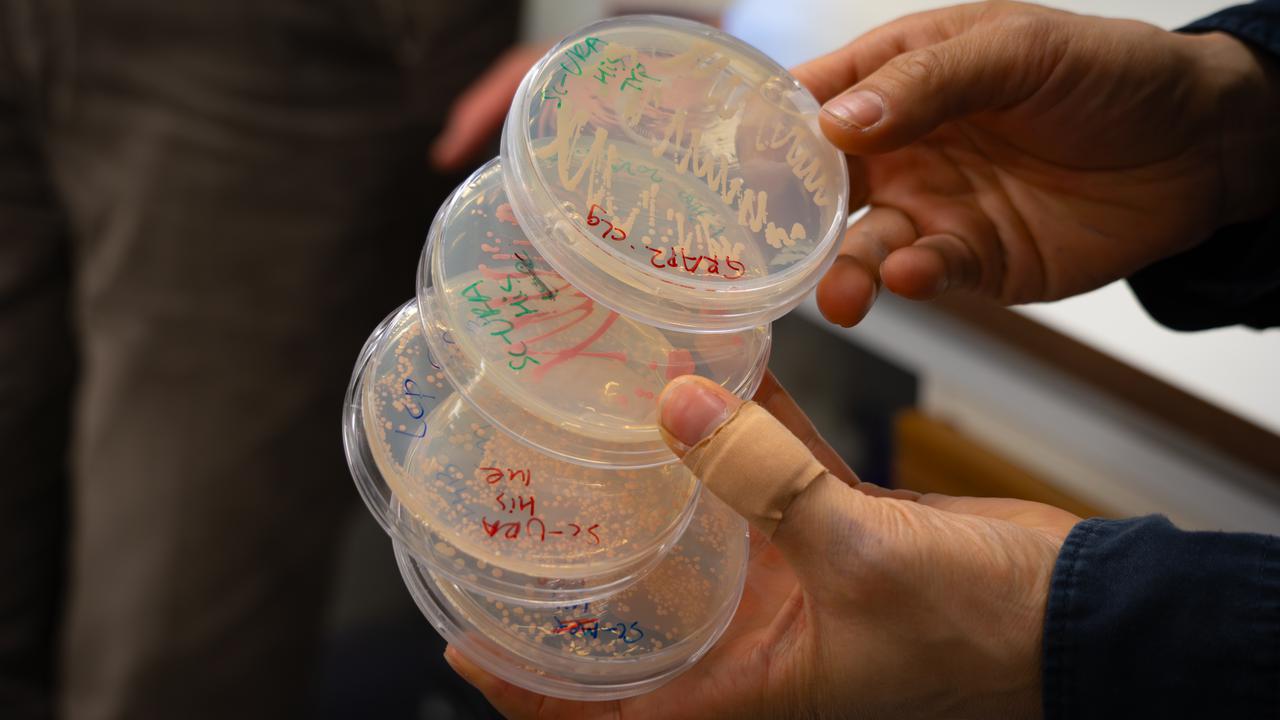
Närbild på fyra petriskålar med jästceller, noggrant uppmärkta.

Du surfar just nu på en begränsad version av umu.se. Vad innebär det här?

Viktiga pusselbitar till den banbrytande gensaxen upptäcktes i Umeå. I dag används verktyget till mycket.

Den nobelprisbelönade gensaxen har nu för första gången börjat användas för behandling av sjukdom.

Tre unga forskare är utsedda till Wallenberg Academy Fellows av Knut och Alice Wallenbergs Stiftelse.
Vid Umeå universitet pågår ett flerfrontskrig för att bekämpa anorexi.

Nu inleds en omstrukturering av Medicinska biblioteket med fokus på att utveckla studieplatserna.

Vad händer när ett verktyg som ska utmana normer i stället riskerar att återskapa dem? Ny forskning ger svar.

Akademisk frihet och dess utmaningar diskuterades i ”Curie Talks” vid Umeå universitet.

Bo i lägenhet, studentrum eller kollektiv? Tips för dig som söker bostad i Umeå.

Realityserie från Umeå universitet.

Umeå universitet har höga ambitioner för att bidra aktivt till en hållbar samhällsutveckling.

Universitetets vision och värdegrund sätter grunden för hur vi vill vara, mot varandra och gentemot omvärlden.

På vilket sätt vill du bidra till forskning och utveckling genom Umeå universitet?